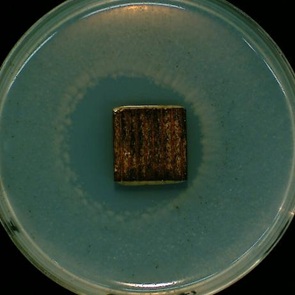

高性能で環境に優しい木材防腐防虫剤「水性クレオトップ」
水性クレオトップについて
水性クレオトップは木材防腐剤、防虫剤、防かび剤で、木材を腐らせる木材腐朽菌、シロアリ他の木材を食べる害虫、かびから木材を守ります。木はCO2を吸収して育ち、炭素として体内に固定化します。この木が伐採されて木材となり、水性クレオトップによって長持ちすれば、大気中のCO2を減らすことができます。水性クレオトップについて詳しく説明します。
水性クレオトップの用途
水性クレオトップはプランター、フラワースタンド、ガーデン家具、ウッドデッキ、フェンス、杭、支柱、防腐木材など、屋外で使われる木製構造物、木製素材の防腐、防虫、防カビ処理に使います。ユーザーはDIY、建築業者、塗装業者を始めとする各種業者だけでなく、工場での防腐処理木材の製造にも広く使われています。コメリさんが販売するエコクレオ防腐杭は、小径材や合板を採った後の芯の部分の材を水性クレオトップ(特注色)に浸漬して製造され、造園や土木、農業用に使われます。エコクレオ防腐杭は、『ウッドデザイン賞2025』奨励賞を受賞しました。水性クレオトップは防腐防虫防かび効果を付与するため他の塗料の下塗りとして使われることもあります。
木製プランター

フラワースタンド
ガーデン家具

ウッドデッキ
フェンス

土木、園芸、農業用杭・支柱

エコクレオ防腐杭の『ウッドデザイン賞2025』受賞式

防腐処理板

木材工場での防腐処理木材の製造
水性クレオトップの特徴
防腐防虫防カビ効果が優れる
水性クレオトップは防腐、防虫、防かび効果があります。効果を証明する試験データについては、次の項で紹介します。効果が証明されているから、DIYだけでなく業務用にも工業用でも使われています。
低臭性
水性クレオトップは油性木材防腐剤と比べて大幅に臭気が抑えられています。だから、室内でも塗ることができます。
乾燥性
水性クレオトップは油性木材防腐剤に比べ、大幅に乾燥時間が短縮されています。そこで、塗装作業が短時間で完了します。生乾きの状態で手に着くこともなくなります。
安全性
水性クレオトップに使われている防腐成分、防虫成分は同じ化学物質が農薬として果樹や野菜、穀物、観葉植物などに使われています。そこで、適正に使用すれば人や環境に優しいものです。また、建築基準法で規制されるホルムアルデヒド放散量は、基準値以下(F☆☆☆☆レベル)であることを試験により確認しています。また、厚生労働省がシックハウス原因物質として室内濃度指針値を設けている13物質を含みません。

作業性
粘度が低く塗りやすい反面、塗装中に垂れることがあります。しかし、低粘度で良く染み込むことが、防腐防虫効果を発揮するために必要です。垂れに気を付けて塗ってください。使用後の刷毛は洗浄のための溶剤は不要で、水で洗うだけなので簡単です。
下塗りとして使用
防腐防虫効果のない他の塗料の下塗りとして使えます。上塗りは水性塗料の方が相性が良いです。
処分法
余ったら塗料固化材で固めて捨ててください。
環境に優しい
水性クレオトップは、揮発して大気汚染や地球温暖化の原因になる溶剤をほとんど含みません。
水性クレオトップの効力
水性クレオトップの優れた効力について、各種の試験結果を基に説明します。
野外杭試験

野外杭試験は木材防腐剤を塗った杭の下半分を土に埋め、木材腐朽菌やシロアチによる被害を観察する試験です。設置から5年1か月経過した杭の被害状況を紹介します。
水性クレオトップは全く被害がありません。

一方、他社の木材防腐剤を塗った杭は、激しい腐朽とシロアリの被害により折れ、原形を留めません。
水性クレオトップは土中に埋めるという厳しい試験でも長期間劣化しないことが証明されました。
この試験結果について詳しくは<こちらから>ご覧ください。
ダブルレイヤー試験

ダブルレイヤー試験は木材防腐剤で処理した木板試験体を半分ずつずらして2段に重ね、屋外に放置して経過を見る試験法です。木材防腐剤がウッドデッキやフェンス、ガーデン家具など木製構築物に使われた場合の耐久性を評価するために有効な試験法です。試験開始から4年6ヶ月経過後の劣化状況を紹介します。

水性クレオトップは両端の水の溜まる部分が塗れていますが、腐っていません。
他社製防腐剤を塗った木材は、両端が腐朽し、木材腐朽菌の白い菌糸や子実体(キノコ)が生えています。
水性クレオトップはウッドデッキなど木製構造物に使われた場合、長期の耐久性があることが証明されました。
この試験について詳しくは<こちらから>ご覧ください。
防腐性能室内試験

JISに規定された試験で、マヨネーズ瓶の中で培養した2種の木材腐朽菌の中に防腐剤を塗布した木片を入れて、12週間後の質量減少率(木材腐朽菌に食われて減少した重量)を量ります。質量減少率が3%以下なら合格です。

水性クレオトップは2種の木材腐朽菌、オオウズラタケ、カワラタケ共に質量減少率が3%以下で、基準に合格しています。
室内防蟻試験

JISに規定された試験で、イエシロアリの飼育容器に防腐剤を塗った木片を入れ、21日後の木片の質量減少率(シロアリに食われた量)を量ります。質量減少率が3%以下なら合格です。

水性クレオトップはシロアリに食われた量が3%以下で、基準に合格しています。
かび抵抗性試験
JASS(日本建築学会規格)に規定された試験で培地に防腐剤を塗布した木片を置き、かびの菌液を吹きかけ、菌糸の発育状況を観察します。試験片に菌糸の発育が認められなければ合格(試験結果0)です。

写真のように水性クレオトップを塗った木片上に菌糸は発育せず、木片を囲んで円形状に阻止帯(発育を阻止している部分)があります。
水性クレオトップの塗装手順
水性クレオトップの塗装手順について、フラワースタンドの製作とガーデン家具の再塗装を例にして説明します。
小物の製作
フラワースタンドの塗装について説明します。
01
サンドペーパーで研磨
サンドペーパーで研磨することによって水性クレオトップが染み込みやすくなります。

02
ヤニ除去
ヤニの出ているところはアルコール(エタノール、消毒用アルコール)で拭き取ります。これを怠ると、水性クレオトップが染み込まないので、防腐防虫効果が発揮されません。

03
削り粉を落とす
ウエス(布)を使ってサンドペーパーで落とした削り粉を拭き取ります。

04
攪拌1
缶を逆さまにしてよく振ります。

05
開缶
缶オープナーかマイナスドライバー(缶オープナー推奨)を水性クレオトップの本体とふたの間に差し込み、てこの原理で持ち上げます。差し込む位置を少しずつ移動し、全周を少しずつ開いていきます。缶の開け方は<こちらから>ご覧ください。

06
攪拌2
割りばしなどで底からよくかき混ぜます。

07
塗布
各パーツに水性クレオトップを塗ります。組み立ててからでは塗れない部分ができてしまうので、組み立てる前に塗ります。良く染み込むように、塗り残しの無いように丁寧に塗ります。特に木口(木の繊維と直角方向に切断した面)は、木材を腐らす腐朽菌や害虫が侵入しやすい部分なので良く染み込ませます。

08
乾燥
弊社では、水性クレオトップを塗ったパーツを、さかさまにした紙コップの上に置いて乾燥させます。2時間以上乾燥させて、2回目を塗ります。必要な量を染み込ませるためと、塗りむらを防ぐため、2回塗りは必ず必要です。2回目を塗ったら、2時間乾燥させてください。

09
完成
パーツを組み立てて、フラワースタンドが完成しました。フラワースタンドの作り方は、<こちらから>ご覧ください。

ガーデン家具の再塗装
ガーデン家具に水性クレオトップを塗って3年経過しました。このガーデン家具の再塗装について説明します。
01
汚れ落とし
先ずは硬めのブラシでこすって汚れを落とします。たわしでも良いです。

01
塗装
テーブルの足の裏を塗っています。ここは、地面と接して水が溜まりやすく、木口なので木材腐朽菌やシロアリが侵入し易い場所です。そこで、念入りに塗って、良く染み込ませます。

01
コテ刷毛による塗装
面積が広く、平らな場所は、コテ刷毛の方が簡単に塗れます。

01
乾燥と2回目の塗装
2時間乾燥させて、2回目を塗り、最後にまた乾かして終了です。塗り替えを定期的に行えば、腐ることも虫に食われることもなく長持ちします。ガーデン家具の作り方は<こちらから>ご覧ください。

まとめ
水性クレオトップは防腐、防虫、防かび効果に優れ、木材を強力に保護します。さらに安全で環境に優しい木材防腐剤です。一方、市販されている木材防腐剤の中には効果の劣る製品が多数あります。ウッドデッキ、フェンスやその他の木製構築物、木製資材を長持ちさせるため、多数の試験データにより効果が実証された、吉田製油所の水性クレオトップをご使用ください。(善)
FAQ よくある質問
Q 水性木材防腐剤は雨が降ったら流れてしまいませんか?
A 固体の有効成分を溶剤に溶かして界面活性剤で水に分散させているため、木に染み込んで溶剤が揮発すると固体に戻り、木の中に固定化され、溶け出しにくくなります。そこで水性木材防腐剤は塗布後乾燥すると雨で流れる心配はありません。
Q 水性木材防腐剤は油性に比べて効果が劣るか
A 水より油の方が木に染み込みやすいので、確かに油性木材防腐剤の方が耐久性がありますが。水性クレオトップは、JISの防腐試験、防蟻試験にも合格し、充分な効果が確認されています。
Q 油性クレオトップとの違い
A 油性クレオトップは野外杭試験で水性クレオトップを上回る防腐効果が確認されていますが、一方で、臭いが強く、色落ちが早い、乾燥が遅いという欠点があります。水性クレオトップは、臭いがほとんどない、色持ちがよい、乾燥が早い、大気汚染や地球温暖化の原因となる溶剤をほとんど含まないという長所があります。
Q 水性クレオトップの使用量
A 水性クレオトップの使用量は2回塗りで140mL/㎡が標準ですが、素材の吸い込みにより異なります。使用量は、「塗る面積×140mL」で計算してください。
Q 塗装間隔
A 水性クレオトップは効果を持続させるため2~3年の間隔で再塗装してください。
Q 水性クレオトップの上に他の塗料を塗れるか
A 完全に乾けば他の塗料を上塗りできますが、油性塗料よりも水性塗料を塗る方が相性が良いです。
Q クレオソート油やクレオトップの上に水性クレオトップが塗れるか
A 未乾燥のクレオソート油や油性クレオトップの上には弾いてしまって塗れませんが、数年経過して完全に乾いていれば、水性クレオトップを上塗りすることができます。
Q 水性クレオトップの他の容器への移し方
A 0.7L缶、2L缶は移し変えずにそのまま刷毛を挿入します。14L缶は注ぎ口が上になるようにするとスムーズに注げます。逆に注ぎ口を下にすると、空気の出入りによって出てくる液が波打ち、まき散らしてしまいます。詳しくは<こちらから>ご覧ください。
Q 余った時の処分法
A ホームセンターなどで販売されている塗料固化剤を使って固めて捨ててください。詳しくは<こちらから>ご覧ください。
Q 水性クレオトップはF☆☆☆☆か
A 水性クレオトップはF☆☆☆☆の登録はありません。 建築基準法によるホルムアルデヒド規制は、ホルムアルデヒドを発散する可能性がある塗料、接着剤、合板などの建築材料を指定して規制した物で、元々ホルムアルデヒドが発生する可能性のなかった木材防腐剤は対象外であり、登録もできません。弊社の木材防腐剤はホルムアルデヒドを原料として使わず、発散しないことを試験で確認済みです。
Q 水性クレオトップはK3の防腐剤か
A K3の防腐剤というものは存在しません。K3は、JASが規定する保存処理木材の規格であって、薬剤の規格ではありません。
水性クレオトップパンフレット
木材を強力に保護する水性クレオトップ。防腐、防虫、防かび効果に優れ、安全で環境に優しい木材防腐剤です。
- 防腐、防虫、防かび効果に優れます。
- 臭いがほとんどありません。
- 安全性が高い。
- 作業性が良好。
- 溶剤をほとんど含みません。
